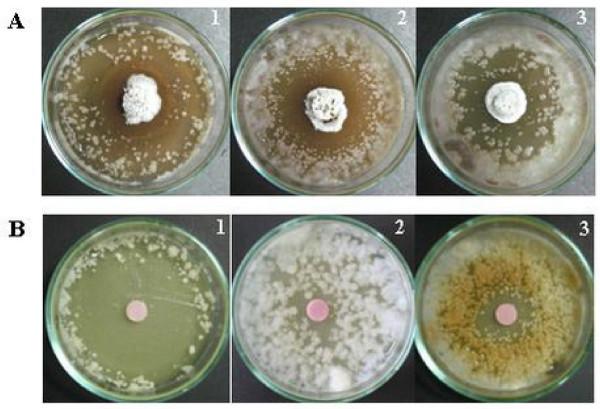

从植物根际土壤中鉴定出对炭疽病病原体炭疽菌属具有抑制活性的放线菌。
Identification of actinomycetes from plant rhizospheric soils with inhibitory activity against Colletotrichum spp., the causative agent of anthracnose disease.
作者信息
Intra Bungonsiri, Mungsuntisuk Isada, Nihira Takuya, Igarashi Yasuhiro, Panbangred Watanalai
机构信息
Department of Biotechnology, Faculty of Science, Mahidol University, Bangkok 10400, Thailand.
出版信息
BMC Res Notes. 2011 Apr 1;4:98. doi: 10.1186/1756-0500-4-98.
BACKGROUND
Colletotrichum is one of the most widespread and important genus of plant pathogenic fungi worldwide. Various species of Colletotrichum are the causative agents of anthracnose disease in plants, which is a severe problem to agricultural crops particularly in Thailand. These phytopathogens are usually controlled using chemicals; however, the use of these agents can lead to environmental pollution. Potential non-chemical control strategies for anthracnose disease include the use of bacteria capable of producing anti-fungal compounds such as actinomycetes spp., that comprise a large group of filamentous, Gram positive bacteria from soil. The aim of this study was to isolate actinomycetes capable of inhibiting the growth of Colletotrichum spp, and to analyze the diversity of actinomycetes from plant rhizospheric soil.
RESULTS
A total of 304 actinomycetes were isolated and tested for their inhibitory activity against Colletotrichum gloeosporioides strains DoA d0762 and DoA c1060 and Colletotrichum capsici strain DoA c1511 which cause anthracnose disease as well as the non-pathogenic Saccharomyces cerevisiae strain IFO 10217. Most isolates (222 out of 304, 73.0%) were active against at least one indicator fungus or yeast. Fifty four (17.8%) were active against three anthracnose fungi and 17 (5.6%) could inhibit the growth of all three fungi and S. cerevisiae used in the test. Detailed analysis on 30 selected isolates from an orchard at Chanthaburi using the comparison of 16S rRNA gene sequences revealed that most of the isolates (87%) belong to the genus Streptomyces sp., while one each belongs to Saccharopolyspora (strain SB-2) and Nocardiopsis (strain CM-2) and two to Nocardia (strains BP-3 and LK-1). Strains LC-1, LC-4, JF-1, SC-1 and MG-1 exerted high inhibitory activity against all three anthracnose fungi and yeast. In addition, the organic solvent extracts prepared from these five strains inhibited conidial growth of the three indicator fungi. Preliminary analysis of crude extracts by high performance liquid chromatography (HPLC) indicated that the sample from strain JF-1 may contain a novel compound. Phylogenetic analysis revealed that this strain is closely related to Streptomyces cavurensis NRRL 2740 with 99.8% DNA homology of 16S rRNA gene (500 bp).
CONCLUSION
The present study suggests that rhizospheric soil is an attractive source for the discovery of a large number of actinomycetes with activity against Colletotrichum spp. An interesting strain (JF-1) with high inhibitory activity has the potential to produce a new compound that may be useful in the control of Colletotrichum spp.
背景
炭疽菌属是全球分布最广且最重要的植物病原真菌属之一。炭疽菌属的多种菌种是植物炭疽病的病原体,这对农作物来说是个严重问题,在泰国尤为如此。这些植物病原体通常使用化学药剂进行防治;然而,使用这些药剂会导致环境污染。炭疽病潜在的非化学防治策略包括使用能够产生抗真菌化合物的细菌,如放线菌属,放线菌是一大类来自土壤的丝状革兰氏阳性细菌。本研究的目的是分离能够抑制炭疽菌属生长的放线菌,并分析植物根际土壤中放线菌的多样性。
结果
共分离出304株放线菌,并测试了它们对引起炭疽病的胶孢炭疽菌菌株DoA d0762和DoA c1060、辣椒炭疽菌菌株DoA c1511以及非致病性酿酒酵母菌株IFO 10217的抑制活性。大多数分离株(304株中的222株,占73.0%)对至少一种指示真菌或酵母有活性。54株(占17.8%)对三种炭疽病菌有活性,17株(占5.6%)能够抑制测试中所有三种真菌以及酿酒酵母的生长。对尖竹汶府一个果园中挑选的30株分离株进行16S rRNA基因序列比较的详细分析表明,大多数分离株(87%)属于链霉菌属,而一株属于糖多孢菌属(菌株SB - 2),一株属于诺卡氏菌属(菌株CM - 2),两株属于诺卡菌属(菌株BP - 3和LK - 1)。菌株LC - 1、LC - 4、JF - 1、SC - 1和MG - 1对所有三种炭疽病菌和酵母都具有高抑制活性。此外,从这五株菌株制备的有机溶剂提取物抑制了三种指示真菌的分生孢子生长。通过高效液相色谱(HPLC)对粗提物进行的初步分析表明,菌株JF - 1的样品可能含有一种新化合物。系统发育分析表明,该菌株与卡沃链霉菌NRRL 2740密切相关,16S rRNA基因(500 bp)的DNA同源性为99.8%。
结论
本研究表明,根际土壤是发现大量对炭疽菌属有活性的放线菌的一个有吸引力的来源。一株具有高抑制活性的有趣菌株(JF - 1)有可能产生一种可用于防治炭疽菌属的新化合物。